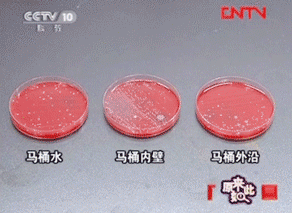

【品名】inwejia魔瓶洁厕灵
原价:49元
活动价:39元
直播最低价:39元
成本:27元
活动毛利:30.77%
直播毛利:30.77%
规格:两瓶装,每瓶250g
旧包装保质期:3年
新包装保质期:2年
发货地:北京
物流:韵达,偏远地区不发货,发货时效正常48小时内。
产品短链接:https://j.youzan.com/RXrK7s
【产品介绍】
1、INWEJIA,一个追求按需购买的日本人气家居清洁品牌。提供上百种家居清洁组合方案,因为设计大方、简单好用、性价比极高,成为知名“主妇帮手”。常居畅销榜的魔瓶清洁凝胶是他们家的明星产品。
2、和市面上普通的洁厕灵不太一样,这款是凝胶配方,微孔自动释放,摒弃传统固体清洁配方,拒绝挂壁无残留。
3、传统的洁厕灵使用周期短,气味难闻,易沾手。强酸强碱容易伤马桶伤皮肤,清洁力还不够。
4、这款小魔瓶健康环保,去污力强,除臭清香,清洁力强还不伤釉面。
5、只需放入马桶水箱中,就能立享全方位清洁。冲一次水等于清洁一次马桶,每次冲洗它都能清理马桶,除垢除臭。
它能均匀冲厕1588次,超级省心省力,仅需半年换一次。
6、PH值中性,温和无刺激不伤皮肤。防止细菌滋生,除菌率检测达到99.9%。还家人一个健康的卫生环境,家里有宝宝的更应该注意。
7、有效清除下水道臭气回窜,分解马桶异味,再也不用屏住呼吸上厕所,还你厕所清新自然风。
8、均匀溶解不沾壁,采用浓缩液体,无残留不留渣。去除污垢,釉面形成保护膜!经常使用能使马桶壁上的尿垢一层层剥离。马桶、水管水箱持久清洁。
9、使用起来非常方便,只需将魔瓶封条撕开,将魔瓶整个顶部盖子取掉,直接放入马桶水箱后盖上盖子静置5分钟就OK了,带水箱的马桶及蹲便都能使用。

-----------------分割线-----------------
!!图片灵活运用!!
【朋友圈】
宁洗100次碗,也不愿意刷一次马桶
这个小魔瓶安利个所有懒癌星人
冲洗不挂壁,味道很清晰,孕妇小孩可用
价格也很美丽,一组2瓶,承包卫生间一年的马桶清洁
原价49元
粉丝专享价2瓶只要39元
购买链接:https://j.youzan.com/RXrK7s
绝对是无限回购的家居清洁好物~




【社群--要分段插图!!】
在洗马桶这件事上,我是宁愿洗100次碗,也不愿意刷一次马桶
这个小魔瓶就帮我解决了洗马桶的烦恼
自用一瓶,比市面上其他洁厕剂要好用
味道很清新,冲洗不会挂壁
使用时间持久,一个能冲1588次,差不多半年不用换,超方便了
价格也很美丽,一组2瓶,承包卫生间一年的马桶清洁
原价49元
现在社群福利2瓶只要39元
购买链接:https://j.youzan.com/RXrK7s
绝对是无限回购的家居清洁好物~





【用户晒图】



【其他可用素材】
--资质安全


--图片素材










【产品拓展素材】
--马桶上的细菌
有研究指出,刚刚冲完的马桶内壁上,病菌数量仍高达10万个。
央视一档叫《原来如此》的节目,曾经做过关于马桶细菌测试的实验。结果发现:马桶内壁的细菌要比马桶外沿和马桶蓄水坑里的还要多。
这些细菌是可以被冲水时产生的强大气流带到空气中到处乱飘的。

--为什么选ph值中性的洁厕剂
这款洁厕剂用天然植物配方用着更安全,PH值中性,温和无刺激不伤皮肤,孕妇和小孩也可以安心使用。
市面上的洁厕灵,近两成产品总酸度超标,如果使用总酸度超标的洁厕灵,不仅马桶瓷面会损坏,还会影响人体健康。
